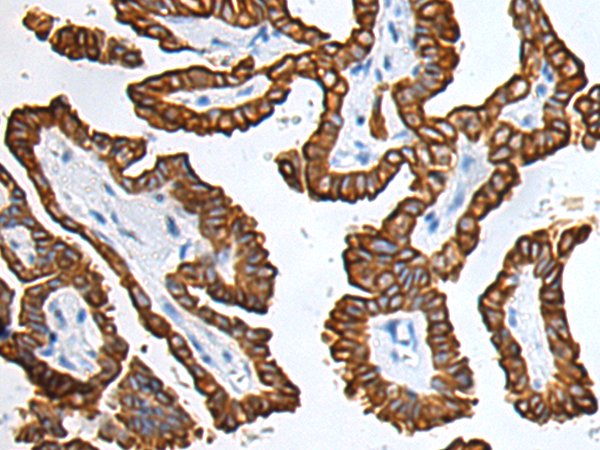

中文名稱:小鼠抗KRT7單克隆抗體
|
Background: |
The protein encoded by this gene is a member of the keratin gene family. The type II cytokeratins consist of basic or neutral proteins which are arranged in pairs of heterotypic keratin chains coexpressed during differentiation of simple and stratified epithelial tissues. This type II cytokeratin is specifically expressed in the simple epithelia lining the cavities of the internal organs and in the gland ducts and blood vessels. The genes encoding the type II cytokeratins are clustered in a region of chromosome 12q12-q13. Alternative splicing may result in several transcript variants; however, not all variants have been fully described. [provided by RefSeq, Jul 2008]. |
|
Applications: |
WB, IHC, FC |
|
Name of antibody: |
KRT7 |
|
Immunogen: |
Fusion protein of human KRT7 |
|
Full name: |
keratin 7, type II (KRT7) |
|
Synonyms: |
CK7; K2C7; K7; SCL |
|
SwissProt: |
P08729 |
|
IHC positive control: |
human kidney tissue and carcinoma of human lung tissue |
|
IHC Recommend dilution: |
30-150 |
|
WB Predicted band size: |
51 kDa |
|
WB Positive control: |
A549 cell lysate |
|
WB Recommended dilution: |
500-2000 |

購物車
幫助
021-54845833/15800441009
